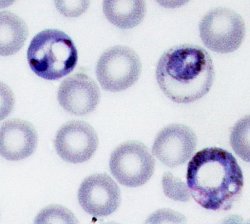

SICB Annual Meeting 2011
January 3-7, 2011
Salt Lake City, UT
 A wide variety of infectious diseases (e.g., AIDS, influenza, West Nile virus) display pronounced fluctuations in response to environmental changes in both humans and non-human animals. Disease susceptibility is a function not only of pathogen dynamics including prevalence and virulence (disease ecology), but is also driven by the internal physiological state of an individual, including host immune function (eco-immunology). Despite the interconnectedness between these two disciplines the majority of research has traditionally focused on only one level of analysis, either ultimate (evolution and ecology of parasites and their effects on life histories) or a proximate (how environmental variables affect function immune responses across taxa). However, the effects of ecological and evolutionary factors affecting susceptibility to disease are driven not only by environmental variation in diseases and their vectors but also by differences in host immune function that alters disease susceptibility across individuals. Despite the necessary interconnectedness between the two disciples of eco-immunology and disease ecology, surprisingly little cross-talk occurs between these fields.
The overarching goal of the proposed symposium is to critically review recent advances in the disciplines of eco-immunity and disease ecology, and also to attempt to integrate both the proximate and ultimate perspectives into a common theoretical framework.
A wide variety of infectious diseases (e.g., AIDS, influenza, West Nile virus) display pronounced fluctuations in response to environmental changes in both humans and non-human animals. Disease susceptibility is a function not only of pathogen dynamics including prevalence and virulence (disease ecology), but is also driven by the internal physiological state of an individual, including host immune function (eco-immunology). Despite the interconnectedness between these two disciplines the majority of research has traditionally focused on only one level of analysis, either ultimate (evolution and ecology of parasites and their effects on life histories) or a proximate (how environmental variables affect function immune responses across taxa). However, the effects of ecological and evolutionary factors affecting susceptibility to disease are driven not only by environmental variation in diseases and their vectors but also by differences in host immune function that alters disease susceptibility across individuals. Despite the necessary interconnectedness between the two disciples of eco-immunology and disease ecology, surprisingly little cross-talk occurs between these fields.
The overarching goal of the proposed symposium is to critically review recent advances in the disciplines of eco-immunity and disease ecology, and also to attempt to integrate both the proximate and ultimate perspectives into a common theoretical framework.
Sponsors
This symposium is sponsored by the following divisions: DCE, DEE
Organizers
- Susannah French, Utah State University
- Denise Dearing, University of Utah
- Gregory Demas, Indiana University
Outline of Program